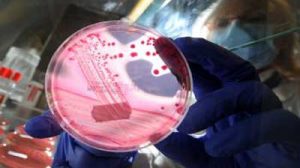

أسفرت أبحاث موسّعة أجراها علماء بولنديون عن اكتشاف واعدٍ من المتوقع أن يؤدي إلى الاستعاضة عن العقاقير الكيميائية المضادة للسرطانات بمستخلصات عضوية فعالة توجد في أنواع عدة من الخضراوات الإشاعة، بما في ذلك البطاطس والطماطم والباذنجان والفلفل وأنواع معينة من التوت. العلماء ذكروا في سياق ورقة بحثية أن...